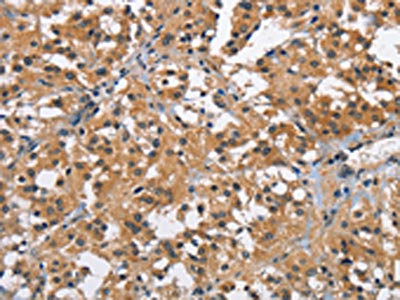

BRE Antibody
-
中文名稱:BRE兔多克隆抗體
-
貨號:CSB-PA047722
-
規格:¥1100
-
圖片:
-
The image on the left is immunohistochemistry of paraffin-embedded Human liver cancer tissue using CSB-PA047722(BRE Antibody) at dilution 1/40, on the right is treated with fusion protein. (Original magnification: ×200)
-
The image on the left is immunohistochemistry of paraffin-embedded Human thyroid cancer tissue using CSB-PA047722(BRE Antibody) at dilution 1/40, on the right is treated with fusion protein. (Original magnification: ×200)
-
Gel: 8%SDS-PAGE, Lysate: 40 μg, Lane: A431 cells, Primary antibody: CSB-PA047722(BRE Antibody) at dilution 1/750, Secondary antibody: Goat anti rabbit IgG at 1/8000 dilution, Exposure time: 30 seconds
-
-
其他:
產品詳情
-
Uniprot No.:
-
基因名:
-
別名:6030405P19Rik antibody; AI429776 antibody; B830038C02Rik antibody; Brain and reproductive organ expressed (TNFRSF1A modulator) antibody; brain and reproductive organ expressed protein antibody; Brain and reproductive organ-expressed protein antibody; BRCA1 A complex subunit BRE antibody; BRCA1-A complex subunit BRE antibody; BRCA1/BRCA2 containing complex subunit 4 antibody; BRCA1/BRCA2 containing complex subunit 45 antibody; BRCA1/BRCA2-containing complex subunit 45 antibody; BRCC4 antibody; BRCC45 antibody; bre antibody; BRE_HUMAN antibody
-
宿主:Rabbit
-
反應種屬:Human,Mouse,Rat
-
免疫原:Fusion protein of Human BRE
-
免疫原種屬:Homo sapiens (Human)
-
標記方式:Non-conjugated
-
抗體亞型:IgG
-
純化方式:Antigen affinity purification
-
濃度:It differs from different batches. Please contact us to confirm it.
-
保存緩沖液:-20°C, pH7.4 PBS, 0.05% NaN3, 40% Glycerol
-
產品提供形式:Liquid
-
應用范圍:ELISA,WB,IHC
-
推薦稀釋比:
Application Recommended Dilution ELISA 1:2000-1:5000 WB 1:500-1:2000 IHC 1:50-1:200 -
Protocols:
-
儲存條件:Upon receipt, store at -20°C or -80°C. Avoid repeated freeze.
-
貨期:Basically, we can dispatch the products out in 1-3 working days after receiving your orders. Delivery time maybe differs from different purchasing way or location, please kindly consult your local distributors for specific delivery time.
-
用途:For Research Use Only. Not for use in diagnostic or therapeutic procedures.
相關產品
靶點詳情
-
功能:Component of the BRCA1-A complex, a complex that specifically recognizes 'Lys-63'-linked ubiquitinated histones H2A and H2AX at DNA lesions sites, leading to target the BRCA1-BARD1 heterodimer to sites of DNA damage at double-strand breaks (DSBs). The BRCA1-A complex also possesses deubiquitinase activity that specifically removes 'Lys-63'-linked ubiquitin on histones H2A and H2AX. In the BRCA1-A complex, it acts as an adapter that bridges the interaction between BABAM1/NBA1 and the rest of the complex, thereby being required for the complex integrity and modulating the E3 ubiquitin ligase activity of the BRCA1-BARD1 heterodimer. Component of the BRISC complex, a multiprotein complex that specifically cleaves 'Lys-63'-linked ubiquitin in various substrates. Within the BRISC complex, acts as an adapter that bridges the interaction between BABAM1/NBA1 and the rest of the complex, thereby being required for the complex integrity. The BRISC complex is required for normal mitotic spindle assembly and microtubule attachment to kinetochores via its role in deubiquitinating NUMA1. The BRISC complex plays a role in interferon signaling via its role in the deubiquitination of the interferon receptor IFNAR1; deubiquitination increases IFNAR1 activity by enhancing its stability and cell surface expression. Down-regulates the response to bacterial lipopolysaccharide (LPS) via its role in IFNAR1 deubiquitination. May play a role in homeostasis or cellular differentiation in cells of neural, epithelial and germline origins. May also act as a death receptor-associated anti-apoptotic protein, which inhibits the mitochondrial apoptotic pathway. May regulate TNF-alpha signaling through its interactions with TNFRSF1A; however these effects may be indirect.
-
基因功能參考文獻:
- Results show that BRE expression is regulated by HOTTIP LncRNA. Its over-expression promotes cell proliferation and cell cycle progression inhibiting apoptosis of glioma cells. PMID: 27733185
- High BRE and high EVI1 expression are mutually exclusive in MLL-AF9-positive acute myeloid leukemia patients. PMID: 22555662
- High BRE expression defines a novel subtype of adult acute myeloid leukemia characterized by a favorable prognosis. PMID: 21937695
- NBA1/MERIT40 and BRE interaction is required for the integrity of two distinct deubiquitinating enzyme BRCC36-containing complexes PMID: 21282113
- overexpression of the BRE gene is predominantly found in MLL-rearranged AML with t(9;11)(p22;q23). PMID: 20861917
- A novel stress-responsive gene called BRE which interacts with TNF-receptor-1 and blocks the apoptotic effect of TNF-alpha, was identified. PMID: 19757177
- These results show that BRE over-expression can indeed promote growth, though not initiation, of liver tumors. PMID: 20035718
- BRE mediates antiapoptosis by inhibiting the mitochondrial apoptotic machinery PMID: 15465831
- the enhanced tumor growth is more likely due to the antiapoptotic activity of BRE than any direct effect of the protein on cell proliferation PMID: 15582573
- Antiapoptotic in vivo; Bre levels are regulated post-transcriptionally in the liver, which is not observed in human hepatocellular carcinoma (HCC) and non-HCC cell lines. PMID: 17704801
- results implied that BRE plays a significant role in mediating antiapoptotic and proliferative responses in esophageal carcinoma cells PMID: 18756325
顯示更多
收起更多
-
亞細胞定位:Cytoplasm. Nucleus.
-
蛋白家族:BABAM2 family
-
組織特異性:Expressed in all cell lines examined. Highly expressed in placenta.
-
數據庫鏈接:
Most popular with customers
-
-
YWHAB Recombinant Monoclonal Antibody
Applications: ELISA, WB, IHC, IF, FC
Species Reactivity: Human, Mouse, Rat
-
Phospho-YAP1 (S127) Recombinant Monoclonal Antibody
Applications: ELISA, WB, IHC
Species Reactivity: Human
-
-
-
-
-